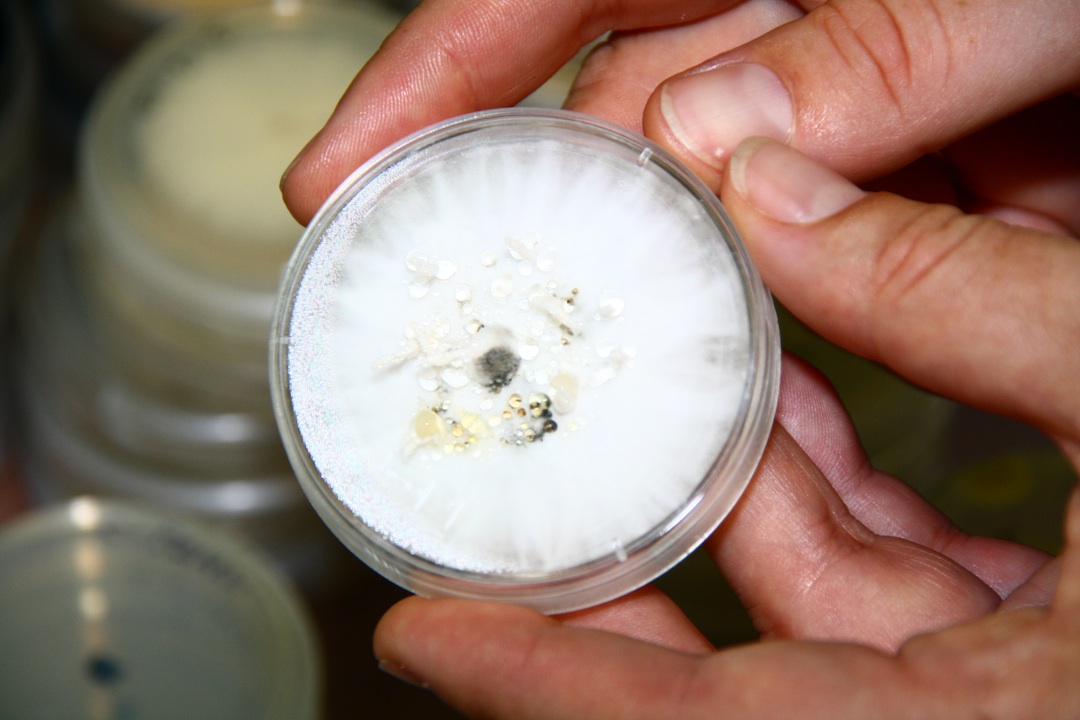
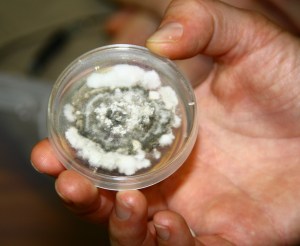

Panama: Imagine being able to fly but giving that up to live deep underground. That’s what a queen leaf-cutter ant does, when she flies to a new nest. She actually bites off her own wings before burrowing into the earth, where she will spend the remaining 12 or so years of her life.

Incredible as this may be, it’s not what draws STRI community ecologist Sunshine Van Bael to Gamboa, which, with 8 species of these neotropical insects, is something of a Mecca to the world’s leaf-cutter ant researchers. Sunshine’s interested in exploring the fungicidal approach the little critters use in their agricultural practices.

Leaf-cutter ants are the world’s most ancient farmers. They’ve been tending their harvests for 50 million years now – considerably longer than humans, whose first agricultural steps were around 10,000 years ago. There’s been no agricultural revolution for the ants, though, farming is remains a considerably labour-intensive affair, whereby the worker ants – all females, like in much of the developing world – travel up to 1 kilometre away to cut fresh leaves to feed the fungal factory in their nest.

“The queen sits back feeding, laying eggs – to produce more workers – and directing the hard grind,” Sunshine says.



The fungus pays the ants for its comfy, well-fed existence by producing a sugar-rich drink for the ant colony. Leaf-cutter ants cannot survive without this syrup, so they cultivate their fungal garden with extreme care – removing parasites, tidying up waste, and keeping bacteria and moulds at bay with various strategies, including secretions of Actinobacteria antibiotic (which is produced by another symbiotic microorganism that lives in the ants’ glands – how awesome are ants!).
While the ant nest is a Russian doll line-up of organisms within organisms, so are the leaves that the ants defoliate, masticate up and feed to their fungus. Leaves, it was discovered in the 1970s, are completely infested with endophytes, fungi that live within the plants and send out spores to feast on its carbohydrates. Trees around here in Gamboa contain around 30 different species of endophyte in just one leaf. In most cases endophytes don’t harm the plant or us when we eat vegetables, but occasionally there’s a baddy. The Salem witch trials were probably sparked by ergot, a poisonous endophyte of rye.
Endophytes appear to offer their host plants some sort of protection from parasites and herbivores in return for their occupation, and endophyte-infected grasses show considerable resistance to certain insect damage. What Sunshine is interested in is how leaf-cutter ants deal with endophytes and whether they pose a contamination problem for the nest fungus.
In their studies, Sunshine and her colleagues have discovered that ants definitely prefer leaves without endophytes. “Given the choice, ants are twice as likely to pick an uncontaminated leaf to take back to the nest. And it takes them twice as long to process leaf material in the nest for their fungus if it contains endophytes,” she says. This processing involves in some way destroying the endophytes, because after 72 hours of contaminated leaf entering the nest, it has effectively no endophyte left.

How the ants can tell from outside whether a leaf is contaminated on the inside remains a mystery. And she is still trying to figure out how the ants deal with the endophytes they take back to the nest. But the work could be important human leaf-cutters too.
It is estimated that leaf-cutter ants cause $1 billion of damage a year to American crops, so finding an ecologically safe way to control ant munching would be great. “Currently, farmers spray fungicide to kill the ants, but that’s very damaging to the ecosystem,” Sunshine says. “If we could find an endophyte they hate, we could perhaps spray crops with that,” she suggests.